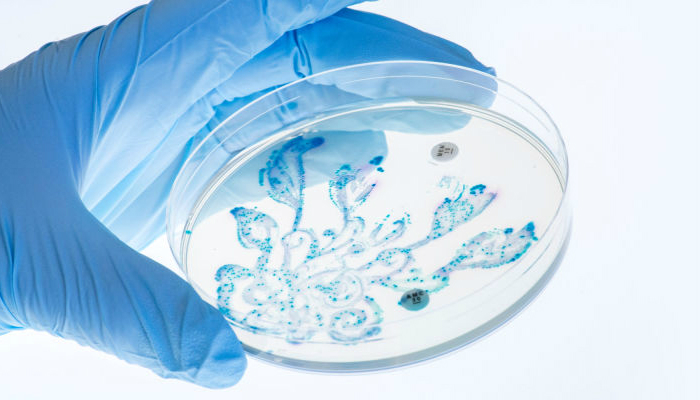
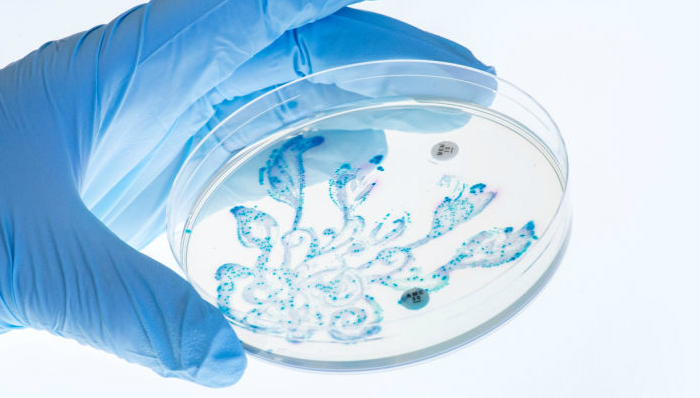
粑粑,肠道细菌,创意,微生物,饮食,健康

粑粑这个话题大家总归是有些忌讳,但它是健康状况的晴雨表,没准还能救你一命。要是看看这几张图片,说不定你还能发现粑粑美丽的一面。
下面的照片都出自牛津大学的Nicola Fawcett博士之手,是美国微生物学会(American Society of Microbiology)举办的琼脂艺术比赛(Agar Art competition)参赛作品——照片的素材,嗯,是粑粑。Fawcett是牛津大学微生物组抗生素抗性研究团队的一员,在那里,她通过分析牛津大学学生的粑粑样本来研究抗生素、饮食、旅行及就医等行为因素对人们肠道细菌的影响。
与Fawcett一起工作的还有艺术家Anna Dumitriu和摄影师Chris Wood,他们将研究成果做成了这一美丽的艺术作品。Fawcett解释道:
这个作品由三种常见的肠道细菌混合而成,其中紫色的是大肠杆菌,蓝绿色的是枸橼酸杆菌,还有很小一部分深蓝色的克雷伯氏菌(大约是其他菌种的五百分之一甚至更少)。首先,将细菌涂在培养皿的琼脂上,静置过夜,以待菌落生长。每一个小小的圆点都是一个菌落(菌落内有上百万个细菌,共同生长)。一般情况下,每个菌落的距离都十分接近,几乎并在一起。你可以看到颜色最多的就是紫色和蓝绿色的菌落,呈压倒性趋势,而深蓝色的克雷伯氏菌落几乎看不见,只有针孔般大小。这与我们肠道内的情况是相似的,有益细菌胜过有害细菌,将它们控制在一定范围内。
这个作品的灵感来源于藤蔓植物,旨在将人们肠道内活跃的细菌呈献在我们眼前。幸运的是,这些菌落看起来的确很美。
Fawcett也专门为她的作品写了详细有趣的说明,包括这个艺术作品是怎么制作的,背后的科学知识及她个人所做的努力。如果你也觉得这些由粑粑勾勒的细菌花园又美又有趣,不妨读一读哦。
(翻译:潘金花)
· · · · · · · · · · · · · · · · · · · · · · · · · · · · · · · · · · · · · · · · · · · · · · · · · · · · · · · · · · ·
想要获取更多有意思的内容,请移步界面网站首页(http://www.jiemian.com/),并在微博上和我们互动,调戏萌萌哒歪楼菌→【歪楼-Viral】(请猛戳这里)。
你也可以关注乐趣频道的微信公众号【歪楼】:esay1414

评论